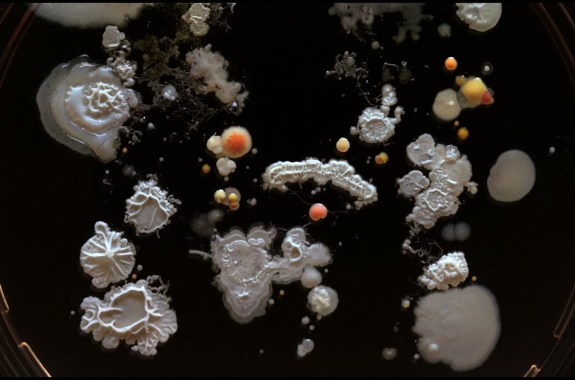
microbiome

featured segment
How to Bring Back the Dead (Animals)
An anatomist’s eye and an artist’s touch are key to creating enduring taxidermy.
7:41
Dormouse Telomeres and Cat Tongues
Most animals’ DNA shortens with age, but scientists are studying an animal that increases its genetic strands as it grows older—the dormouse.
4:20
Not All Soles Are Created Equal
Boots made for extreme winter weather may be easily succumb to an icy sidewalk.
27:44
The Best Science Books Of 2016
Time travel, microbes, black holes, and polar bears.
7:19
Cassini’s Final Year, And Juno’s First
One mission is winding down. Another has just begun. A look at what’s next for each.
12:22
Do You Know What’s in Your Medical Record?
The first step to taking ownership of your medical data is to ask for it. Then it’s up to you how to share and store it.
17:27
Tracking the Daily Rhythms of the Microbiome
How do the circadian rhythms of gut bacteria affect the rest of the body?
17:37
How to Bring Back the Dead (Animals)
An anatomist’s eye and an artist’s touch are key to creating enduring taxidermy.